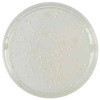
寒天培地特集

絞り込み
価格
培地とは、バイオ・食品などに付着する微生物や生物の培養において、生育環境を提供するもののことをいいます。培地には乾式フィルム状のできあがり培地や粉末状の培地があり、前者は培地調整が不要なので、容易に検査をすることができます。また保管や培養時のスペースを取らず検査工程を簡単にしてくれます。さらに培地には合成培地と半合成培地、天然培地があり、化学薬品のみで調整する培地から天然物そのままで培地を作るものなど用途によって調整します。
「種類」から絞り込む
 ニッスイプレート島津ダイアグノスティクス
ニッスイプレート島津ダイアグノスティクス¥1,198税込¥1,318
1箱(10枚)
当日出荷
日本薬局方準拠培地真菌用
質量(g)400有効期限製造後6ヶ月タイプサブロー寒天培地アズワン品番63-5753-87
 ポアメディア NAC寒天培地 10枚入栄研化学
ポアメディア NAC寒天培地 10枚入栄研化学¥1,398税込¥1,538
1パック(10枚)
5日以内出荷
緑膿菌の選択分離及び鑑別用
仕様●生培地●内容量:10枚アズワン品番65-9539-24保管環境冷蔵
 ポアメディア(R)マンニット食塩培地 10枚入栄研化学
ポアメディア(R)マンニット食塩培地 10枚入栄研化学¥1,398税込¥1,538
1パック(10枚)
5日以内出荷
食塩耐性とマンニット分解性によるブドウ球菌の選択分離用
仕様●生培地●内容量:10枚アズワン品番65-9539-13保管環境冷蔵
 ポアメディア(R)BHI寒天培地 10枚入栄研化学
ポアメディア(R)BHI寒天培地 10枚入栄研化学¥1,498税込¥1,648
1パック(10枚)
5日以内出荷
栄養要求の厳しいレンサ球菌や髄膜炎菌、一般細菌及び真菌の培養と分離用
仕様●生培地●内容量:10枚アズワン品番65-9539-33保管環境冷蔵
 ポアメディア(R)ベアードパーカー寒天培地 10枚入栄研化学
ポアメディア(R)ベアードパーカー寒天培地 10枚入栄研化学¥1,498税込¥1,648
1パック(10枚)
5日以内出荷
黄色ブドウ球菌選択分離用
グリシンと塩化リチウムにより枯草菌や腸球菌などの細菌を抑制
ピルビン酸ナトリウムにより加熱損傷したブドウ球菌を回復
仕様●生培地●内容量:10枚入保存環境冷蔵アズワン品番67-4751-78
 ポアメディア(R)ハートインフュジョン寒天培地 10枚入栄研化学
ポアメディア(R)ハートインフュジョン寒天培地 10枚入栄研化学¥1,398税込¥1,538
1パック(10枚)
5日以内出荷
一般細菌及び栄養要求の厳しい菌や真菌の培養及び分離用
仕様●生培地●内容量:10枚アズワン品番65-9539-32保管環境冷蔵
 ポアメディア カンジダGS培地 10枚入栄研化学
ポアメディア カンジダGS培地 10枚入栄研化学¥1,398税込¥1,538
1パック(10枚)
5日以内出荷
各種検査材料からのカンジダ属の分離用
仕様●生培地●内容量:10枚アズワン品番65-9539-29保管環境冷蔵
 ポアメディア(R)マッコンキー寒天培地 10枚入栄研化学
ポアメディア(R)マッコンキー寒天培地 10枚入栄研化学¥1,298税込¥1,428
1パック(10枚)
5日以内出荷
腸内細菌分離用、組成中の胆汁酸塩によりグラム陽性菌の発育が抑制される
仕様●生培地●内容量:10枚アズワン品番65-9539-17保管環境冷蔵
 ポアメディア(R)CT-SMAC SP寒天培地 10枚入栄研化学
ポアメディア(R)CT-SMAC SP寒天培地 10枚入栄研化学¥1,398税込¥1,538
1パック(10枚)
5日以内出荷
腸管出血性大腸菌O157分離用、ソルビットマッコンキー寒天培地に緑膿菌の抑制力と腸管出血性大腸菌O157集落の視認性を高めて分離効率をよくしている
仕様●生培地●内容量:10枚アズワン品番65-9539-20保管環境冷蔵
 ポアメディア(R)ドリガルスキー改良培地 10枚入栄研化学
ポアメディア(R)ドリガルスキー改良培地 10枚入栄研化学¥1,198税込¥1,318
1パック(10枚)
5日以内出荷
腸内細菌及び一般細菌分離用
仕様●生培地●内容量:10枚アズワン品番65-9539-15保管環境冷蔵
 ポアメディア(R)ミュラーヒントンS寒天培地 10枚入栄研化学
ポアメディア(R)ミュラーヒントンS寒天培地 10枚入栄研化学¥1,298税込¥1,428
1パック(10枚)
5日以内出荷
CLSI Documentに準じた薬剤感受性試験用
仕様●生培地●内容量:10枚アズワン品番65-9539-34保管環境冷蔵
 ポアメディア(R)ドリガルスキー改良培地Blue 10枚入栄研化学
ポアメディア(R)ドリガルスキー改良培地Blue 10枚入栄研化学¥1,198税込¥1,318
1パック(10枚)
5日以内出荷
腸内細菌及び一般細菌分離用
仕様●生培地●内容量:10枚アズワン品番65-9539-16保管環境冷蔵
 ポアメディア(R)サブロー寒天培地 10枚入栄研化学
ポアメディア(R)サブロー寒天培地 10枚入栄研化学¥1,298税込¥1,428
1パック(10枚)
5日以内出荷
多くの真菌の分離、特に酵母の分離・保存用
仕様●生培地●内容量:10枚アズワン品番65-9539-31保管環境冷蔵
 バイメディア(R)5S+A/CT-SMAC SP寒天培地 E-MRシリーズ栄研化学
バイメディア(R)5S+A/CT-SMAC SP寒天培地 E-MRシリーズ栄研化学¥1,198税込¥1,318
1パック(10枚)
5日以内出荷
サルモネラ・シゲラ及びO157分離用分画培地、サルモネラ・シゲラ及びO157の発育支持力と集落の鑑別性能が優れています。緑膿菌の発育抑制力を増強しています。
保存環境冷蔵